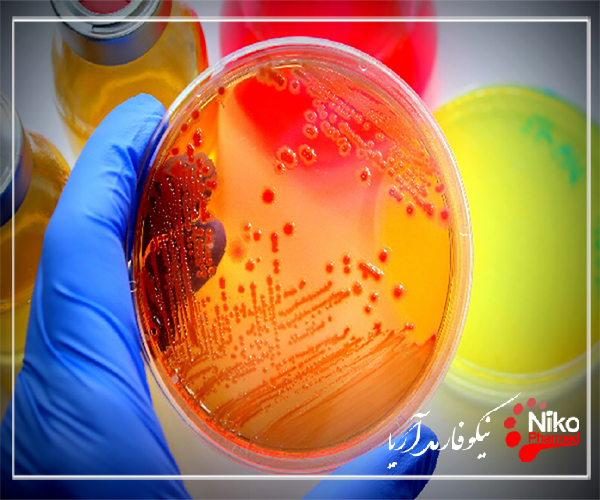
m/پلیت های تماسی حاوی محیط کشت

پلیت های تماسی حاوی محیط کشت؛ نمونه برداری محیطی برای آلاینده های میکروبیولوژیکی جزء کلیدی پایش محیطی و شیوه های شناسایی خطر است که در زمینه های مختلف کاربرد استفاده میشود. بسیاری از تکنیکهای میکروبیولوژیکی برای تأیید روشهای پاک سازی، کنترل تمیزی سطح/هوا، یا ارزیابی سطوح آلودگی میکروبی گزارش شدهاند.
برای خرید پلیت تماسی به این صفحه مراجعه کنید
اتاق های تمیز محیط های بسیار کنترل شده هستند، اما تجهیزات و پرسنل می توانند آلودگی را به این مناطق تولید آسپتیک وارد کنند. بنابراین استفاده از بهترین ابزار برای شناسایی هر گونه فعالیت میکروبی بسیار مهم است. متداول ترین محیط مورد استفاده برای این منظور، تریپتیک سویا آگار (TSA) است، یک محیط غیر انتخابی که به دلیل توانایی اش در اجازه دادن به رشد ارگانیسم های مختلف شناخته شده است.
طبیعت فراگیر میکروارگانیسم ها آنها را قادر می سازد تا مواد مغذی موجود در محیط اطراف خود را تطبیق دهند و از آنها استفاده کنند. در تاسیسات تولیدی، اجرای فرآیندها و سیستم هایی برای جلوگیری از آلودگی میکروارگانیسم ها به محیط های کنترل شده ضروری است. آزمایش و نظارت منظم می تواند به اطمینان از اینکه پروتکل های تمیز کردن و روش های بهداشتی شما به طور مؤثر و مناسب کار می کنند کمک کند. آزمایش صفحه تماس برای سطوحی که در نظر گرفته شده اند عاری از میکروارگانیسم ها باشند یا دارای کنترل دقیق هستند، ایده آل است. به طور خاص به عنوان صفحات RODAC (تشخیص و شمارش ارگانیسم های تکراری) شناخته می شود. آنها برای نظارت میکروبیولوژیکی تمام سطوح استفاده می شوند. شناسایی وجود میکروارگانیسمها به تولیدکنندگان اجازه میدهد تا پروتکلهای بهداشتی سختگیرانهتری ایجاد کنند، روشهای اصلاحی و جلوگیری از آلودگی متقابل محصولات نهایی را انجام دهند.
چرا انجام تست صفحه تماس
روداک پلیت های آماده برای استفاده ما را می توان برای نظارت بر محیطی سطوح در اتاق های تمیز، ایزولاتورها و مناطق غیر بحرانی استفاده کرد. از صفحات تماس معمولاً برای اطمینان از تمیزی اتاق های تمیز، آزمایشگاه ها و غیره استفاده می شود.
تاسیسات تولیدی که روشهای تمیز کردن و ضدعفونی دقیق را اجرا میکنند باید بدانند که همیشه به طور موثر کار میکنند. نظارت و آزمایش منظم برای باکتری ها، مخمرها و کپک ها می تواند به جداسازی مناطقی که نیاز به آموزش مجدد یا نظارت اضافی دارند و همچنین جلوگیری از خاموش شدن، فراخوان یا از دست دادن محصول احتمالی کمک کند. این صفحات تماس با دستور العمل های مختلف رسانه های رشد موجود هستند که به میکروب ها اجازه رشد می دهند.
آزمایش صفحه تماس برای مشتریانی که سطوح بحرانی متعددی دارند که باید عاری از میکروارگانیسم ها باشند یا تحت کنترل دقیق نظارت می شوند، ایده آل است. آنها به بهترین وجه در سطوح صاف و پایدار استفاده می شوند، آزمایش صفحه تماس روی نیمکت های کار، لباس های آزمایشگاهی و مناطق در معرض خطر موثر است.
برای خرید روداک پلیت به این صفحه مراجعه کنید
مقالات بیشتر:
TSA با خنثی کننده ها تکمیل می شود تا با هر گونه عوامل ضد میکروبی مورد استفاده در اتاق تمیز مقابله کند.
صفحات تماس دستگاه های استاندارد برای نظارت بر محیطی سطوح و پرسنل در اتاق های تمیز و ایزولاتورها هستند.
ویژگی های مورد نیاز برای محیط های کشت در ISO 14698 توضیح داده شده است و پایه اعتبار سنجی محیط کشت را نشان می دهد:
رسانه ها باید برای شناسایی طیف وسیعی از میکروارگانیسم ها غیر انتخابی باشند
محیط کشت باید با مواد افزودنی تکمیل شود تا بر فعالیت ضد میکروبی در نقطه نمونه برداری غلبه کند
سطح خارجی ظروف باید در حالت تمیزی متناسب با استفاده از آنها نگهداری شود
صفحات تماس جدید قفل شونده پر شده با TSA و مخلوط خنثی کننده متشکل از لسیتین، پلی سوربات 80، هیستیدین و تیوسولفات سدیم (TSA w. LTHThio cont. - ICR+، مرجع 146783) دارای کیسه سه گانه و پرتودهی گاما برای استفاده در اتاق تمیز یا درجه A هستند.
جدا کننده ها با توجه به سیستم قفل خاص آن ها می توان برای نظارت بر سطح هوازی و بی هوازی و پرسنل استفاده کرد.
بسته بندی سه گانه و تابش گاما با حذف یک لایه بسته بندی در هر قفل مواد، امکان انتقال ایمن صفحات را به اتاق های تمیز و ایزولاتور فراهم می کند.
برای استفاده در ایزولاتورها ثابت شده است که مواد بسته بندی در برابر پراکسید هیدروژن بخار شده غیرقابل نفوذ هستند تا آلودگی ایمن صفحات کیسه ای در ایزولاتور را پاکسازی کنند.
ویژگی های صفحات باید از الزامات ISO 14698 ذکر شده در بالا پیروی کند و دارای راندمان خنثی سازی نسبت به طیف وسیعی از ضدعفونی کننده ها باشد که پرمصرف ترین عوامل فعال را پوشش می دهد.
برای اعتبارسنجی خواص محرک رشد، پانلی از میکروارگانیسمها انتخاب شد که برای آزمایشهای ارتقای رشد رسانه TSA بهعلاوه سویههای آزمایشی اضافی، که بخشی از میکرو فلور معمولی اتاق تمیز را نشان میدهند، توصیه میشود.
برای خرید کانتکت پلیت به این صفحه مراجعه کنید
رایج ترین میکروارگانیسمها در اتاقهای تمیز
رایج ترین میکروارگانیسمها در اتاقهای تمیز، باکتریهای گرم مثبت هستند که توسط Micrococcus spp.، Staphylococcus spp.، Corynebacterium spp غالب هستند.
و به ندرت کپک هایی مانند Aspergillus spp. و Penicillium spp.5 در اعتبار سنجی فعلی، میکروارگانیسمهای زیر در آزمایشهای تقویت رشد گنجانده شدهاند که پس از 0، 3، 6، 9 و 12 ماه نگهداری در مشخصات ذخیره سازی ذکر شده برای هر سه دسته از محیط کشت انجام شد:
باکتری های گرم مثبت غیر سازنده اسپور: کوکوریا ریزوفیلا ATCC 9341، استافیلوکوکوس اورئوس ATCC 6538، استافیلوکوکوس اپیدرمیدیس ATCC 14990
باکتری های گرم مثبت تشکیل دهنده هاگ: باسیلوس سوبتیلیس ATCC 6633، باسیلوس پومیلوس (ایزوله محیطی)، باسیلوس سرئوس ATCC 10876
باکتری های گرم منفی: P. aeruginosa ATCC 9027
مخمر: Candida albicans ATCC 10231
قالب: Aspergillus brasiliensis ATCC 16404
سویه تست بی هوازی: C. sporogenes ATCC 11437
11.16.1 آزمایش صفحه انتشار آگار
گونه های باکتریایی S. aureus (گرم مثبت) و K. pneumonia (گرم منفی) در اکثر روش های آزمایش توصیه می شود. این دو گونه به طور بالقوه بیماری زا هستند و بنابراین برای جابجایی به امکانات فیزیکی مناسبی نیاز دارند (به عنوان مثال، یک کابینت ایمنی زیستی). بسیاری از مطالعات از باکتری E. coli بی ضرر (گرم منفی) به عنوان یک میکروارگانیسم آزمایشی استفاده کرده اند که می تواند در یک آزمایشگاه استاندارد با حداقل خطر سلامتی کشت و نگهداری شود.
یک ژل مغذی حاوی یک میکروارگانیسم روی یک بشقاب ریخته می شود و پس از تنظیم، تکه ای از پارچه مورد بررسی روی سطح ژل قرار می گیرد. سپس کل صفحه تحت شرایط ایده آل برای رشد میکروبی انکوبه می شود. یعنی 18 تا 24 ساعت در دمای 37 درجه سانتی گراد (برای باکتری ها). 3 تا 14 روز در دمای 28 درجه سانتی گراد (برای قارچ ها) یا تا 4 هفته (پارچه های با روکش پی وی سی). نمونه ها همچنین می توانند با آگار بدون مواد مغذی آزمایش شوند تا ببینیم آیا منبع کربنی هستند یا خیر. پس از انکوباسیون کامل، نمونه ها با مقایسه بصری رشد مهار نشده میکروارگانیسم در ظرف و رشد روی پارچه یا در تماس با پارچه ارزیابی می شوند. در صورتی که این نوع ارزیابی مربوط به مواد مورد آزمایش باشد، ارزیابی را می توان با آزمایش کاهش عملکرد از نظر مقاومت کششی یا کاهش وزن نیز انجام داد. ممکن است کاهش رشد یا عدم وجود کامل رشد در نمونه وجود داشته باشد. همچنین ممکن است ناحیه ای از مهار یا "هاله" در اطراف نمونه وجود داشته باشد که در آن زیست کش در ژل پخش شده و از رشد میکروارگانیسم ها جلوگیری کرده است. مناطق بزرگ بازداری مطلوب نیستند. آنها نشان می دهند که یا ماده با بیوسید بارگذاری شده است یا اینکه زیست کش به سرعت و به راحتی در ژل پخش می شود، که نشان دهنده دوام ضعیف پایان است.
تلاش برای درک و درک دنیایی که مردم در آن زندگی می کنند، فرآیندی است که هزاران سال در جریان بوده است. از زمانی که وجود داشته است، همیشه همین سوالات را مطرح کرده است، چه، چرا، چگونه؟ او در این فرآیند به تکرار پذیری تجربیات خود می اندیشید و سعی می کرد افکار خود را عملی کند. مطالعات او باعث آزمایش و مطالعات تجربی شد.
در نتیجه تجربیات قرون گذشته، با پیشرفت علم و فناوری و همچنین یافتن پاسخ برای سؤالات مطرح شده، انسان سعی در حل چگونگی تقلید از طبیعت در محیط آزمایشگاه داشته و به تولید مواد آزمایشی و تجربی پرداخته است. ابزارهایی برای هر قانون طبیعی که او کشف کرده است.
با پیشرفت و گسترش علم، سؤالات افزایش یافته و علوم پایه فیزیک، شیمی و زیست شناسی به حوزه بسیار وسیعی گسترش یافته است. هر کدام از این حوزه ها برای شرایط کاری خاص خود تخصصی شده و آزمایشگاه های مختلفی تشکیل شده است. هر آزمایشگاه با توجه به منطقه کار به مواد و نیازهای دستگاه متفاوتی نیاز دارد.
هنگام کار با محیط ها و معرف هایی که برای کشت میکروارگانیسم ها استفاده می شوند، باید از روش آسپتیک برای اطمینان از به حداقل رساندن آلودگی استفاده کرد. انواع روش های آبکاری به طور معمول برای جداسازی، تکثیر یا شمارش باکتری ها و فاژها استفاده می شود که هر کدام شامل فرآیند هایی برای حفظ عقیمی مواد آزمایش می شود.
میکروارگانیسم ها در همه جا روی سطوح بی جان حضور دارند و منبع احتمالی آلودگی را در آزمایشگاه ایجاد می کنند. موفقیت تجربی در علم استریل کردن سطوح و تجهیزات کار و همچنین جلوگیری از تماس ابزار و محلول استریل با سطوح غیر استریل است. در اینجا ما مراحلی را برای روش های مختلف پوشش که به طور معمول در آزمایشگاه برای جداسازی، تکثیر یا شمارش میکروارگانیسمهایی مانند باکتریها و فاژها استفاده میشود، ارائه میکنیم. هر پنج روش شامل تکنیک آسپتیک یا نگهداری استریل مواد آزمایشی بود. روشهای توصیف شده شامل
(1) کشتهای باکتریایی خطی برای جداسازی کلنیهای منفرد
(2) پلیت ریختن
(3) صفحه پخش برای شمارش کلنیهای باکتریایی زنده، جداسازی فاژ و شمارش پلاکها
(4) روکشهای آگار نرم
(5) replicate برای انتقال یک الگوی فضایی یکسان از صفحه آبکاری شده به سلول های دیگر.
این روش ها را می توان بر روی میز آزمایشگاه انجام داد، به شرطی که شامل سویه های غیر بیماری زای میکروارگانیسمها باشد.
کار با ارگانیسم های BSL-2، پس این دستکاری ها باید در یک کابینت ایمنی زیستی انجام شود. با جدید ترین نسخه ایمنی زیستی در آزمایشگاه های میکروبیولوژیکی و زیست پزشکی و همچنین برگههای اطلاعات ایمنی مواد برای مواد عفونی برای شناسایی اقدامات احتیاطی ایمنی و امکانات مهار میکروارگانیسم مورد نظر، و همچنین طبقهبندی خطرات زیستی، مشورت کنید. سویههای باکتریایی و ذخایر فاژ از محققان، شرکتها و مجموعههایی در دسترس هستند که توسط سازمانهای خاصی مانند مجموعه نیکوفارمد انجام می شوند. توصیه می شود در هنگام یادگیری روش های مختلف آبکاری از سویه های غیر بیماری زا استفاده شود.
مقالات بیشتر:
تست خون سازگاری و هولیز کنندگی
تشخیص اشرشیا کلی در محصولات پزشکی

پروتکل
- یک فضای کار ایمن و استریل آماده کنید
هنگام کار با میکروارگانیسم ها با تمام قوانین آزمایشگاهی و اقدامات احتیاطی ایمنی آشنا شوید. صرف نظر از طبقه بندی خطرات زیستی، تمام موادی که در تماس با میکروارگانیسم ها قرار می گیرند زباله عفونی محسوب می شوند و باید قبل از فروش ضدعفونی شوند. دستورالعمل های ایمنی مناسب ارائه شده توسط دپارتمان های بهداشت و ایمنی محیطی شرکت را برای تنظیم ظروف زباله مناسب برای دفع سریع و مناسب مواد بالقوه آلوده (خطرات زیستی) دنبال کنید.
رسانه ها را با استفاده از آن ها برای همه ابزارها، محلول ها و فرآیندهای قبل از پوشش استریل کنید.
تمام مواد را از گرفتگی محل کار روی نیمکت آزمایشگاه پاک کنید.
محل کار را با مواد ضد عفونی کننده تمیز کنید تا احتمال آلودگی به حداقل برسد.
فضای کاری را در یک کابینت ایمنی زیستی تنظیم کنید و با ارگانیسمهای BSL-2 کار کنید. نمی توان از آن در کابینت مشعل استفاده کرد زیرا شعله جریان هوای مورد نیاز برای عملکرد گرما را مختل می کند.
تمام مواد مورد نیاز برای این روش را روی نیمکت آزمایشگاه نزدیک زمین استریل بچینید. مطمئن شوید که همه مواد به درستی برچسب گذاری شده اند. سازماندهی منطقه کار برای به حداکثر رساندن راندمان کار و اجتناب از جابجایی های غیر ضروری، زمان قرار گرفتن مواد آزمایشی در معرض آلاینده های موجود در هوا را به حداقل می رساند.
مشعل مخصوص را در سمت راست خود روی نیمکت قرار دهید.
بشقاب های آگار یا ظروف پتری را به سمت چپ ردیف کنید.
کشت های سلولی، لوله ها، فلاسک ها و فلاسک ها را در مرکز نیمکت بچینید.
لوله ها، ویال ها و درب بطری ها را شل کنید تا در حین دستکاری های بعدی به راحتی با یک دست باز شوند.
قبل از دست زدن به میکروارگانیسم ها دست ها را با صابون ضد عفونی کننده و آب گرم کاملا بشویید.
- روش جداسازی کلنی های باکتری با استفاده از روش Quadrant
روش streak-plate برای جداسازی کشت های خالص باکتریایی یا کلنی ها از جمعیت های مخلوط با جداسازی مکانیکی ساده طراحی شده است. متشکل از کلنی های منفرد یا میلیون ها سلول است که به صورت توده ای در یک صفحه آگار رشد می کنند. یک کلنی، بر خلاف یک سلول، با چشم غیرمسلح قابل مشاهده است. از نظر تئوری، یک کلنی کلون یا خوشه ای از سلول های ژنتیکی یکسان نامیده می شود، به طوری که تمام سلول ها از یک باکتری منفرد که در ابتدا روی صفحه رسوب کرده است، به دست می آیند.
باکتری ها در اشکال و اندازه های مختلفی وجود دارند. به عنوان مثال، سلول های اشرشیاکلی منفرد به طول میله ای با عرض متوسط 2 میکرومتر و 0.5 میکرومتر هستند در حالی که سلول های استرپتوکوک کروی با قطر متوسط 1 میکرومتر هستند. برخی از باکتری ها (مانند suE. ch. coli) به صورت تک سلولی وجود دارند، در حالی که برخی دیگر اساساً الگوهای متفاوتی را تشکیل می دهند. به طور کلی فرض بر این است که یک کلنی منفرد از یک سلول منفرد که تحت شکافت دوتایی قرار میگیرد به وجود میآید، اما این فرض برای باکتریهایی که به این صورت تقسیم میشوند توسط جفتها، زنجیرهها یا خوشههای طبیعی یا مکانیسمهای دیگر صادق نیست. پوشش دهی چند باکتریایی متناوب می تواند احتمال تشکیل دو یا چند باکتری در بالای سلول ها را افزایش دهد و منجر به ایجاد یک کلنی منفرد شود. برای جلوگیری از این عوارض، کلنی ها را واحدهای تشکیل دهنده کلنی (cfu) می نامند.
برای خرید روداک پلیت به این صفحه مراجعه کنید





